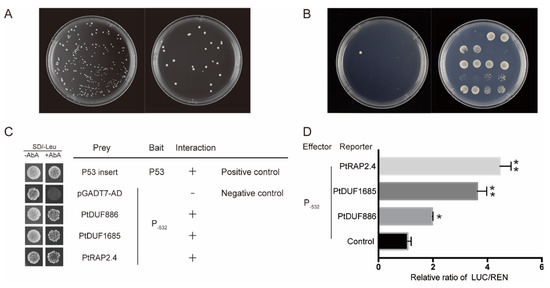

Abstract
Jasmonic acid (JA) plays a crucial role in various biological processes including development, signal transduction and stress response. Allene oxide synthase (AOS) catalyzing (13S)-hydroperoxyoctadecatrienoic acid (13-HPOT) to an unstable allene oxide is involved in the first step of JA biosynthesis. Here, we isolated the PtAOS1 gene and its promoter from trifoliate orange (Poncirus trifoliata). PtAOS1 contains a putative chloroplast targeting sequence in N-terminal and shows relative to pistachio (Pistacia vera) AOS. A number of stress-, light- and hormone-related cis-elements were found in the PtAOS1 promoter which may be responsible for the up-regulation of PtAOS1 under drought and JA treatments. Transient expression in tobacco (Nicotiana benthamiana) demonstrated that the P−532 (−532 to +1) fragment conferring drive activity was a core region in the PtAOS1 promoter. Using yeast one-hybrid, three novel proteins, PtDUF886, PtDUF1685 and PtRAP2.4, binding to P−532 were identified. The dual luciferase assay in tobacco illustrated that all three transcription factors could enhance PtAOS1 promoter activity. Genes PtDUF1685 and PtRAP2.4 shared an expression pattern which was induced significantly by drought stress. These findings should be available evidence for trifoliate orange responding to drought through JA modulation.
1. Introduction
In the south of China, seasonal drought happening from July to September generally damages the citrus industry regularly. Trifoliate orange (Poncirus trifoliata) is the main citrus rootstock in China because of its excellent tolerance or resistance to stresses including drought. However, its specific mechanism in drought tolerance is still not known well. Jasmonic acid (JA) is a kind of octadecanoid derivative synthesized from α-linolenic acid and released from galactolipids of chloroplast membranes. JA and its derivatives (JAs) serve as signaling molecules to regulate diverse aspects of plant life including leaf senescence [1], tuber formation [2], tendril coiling [3], filament elongation [4], biotic and abiotic responses [5,6,7].
JAs play positive roles in plants’ abiotic stress response. Previous studies demonstrated JA or MeJA could modulate plant physiological responses to abiotic stress. For instance, exogenous JA induced rapeseed seedlings’ higher tolerance to drought through improvements in fresh weight, chlorophyll content and relative water content [8]. Improvement in drought tolerance lead by exogenous MeJA was also found in wheat [9] and soybean [10]. On the other hand, stress was followed by endogenous JAs accumulation in most cases, which implied JA could act a positive regulator in stress tolerance [11]. Salt-tolerant tomatoes exhibited higher endogenous JA under whatever normal condition or salt treatment [12]. Salt-resistant mazes differed in JA content at the first phase of salt stress and that might work through Na+ uptake reduction but exclusion improvement in the roots [13]. Moreover, MeJA enhanced salt tolerance in wheat seedlings through decreases in H2O2 and MDA, and increments of antioxidant activities including POD, CAT and APX [14]. In a JA-deficient tomato, activity decreases in antioxidants accelerated oxidative stress by salt treatment, indicating that endogenous JA might play a positive role in plant salt tolerance [15].
Allene oxide synthase (AOS) converting (13S)-hydroperoxyoctadecatrienoic acid (13-HPOT) to an unstable allene oxide is involved in the first step of JA biosynthesis. AOS belongs to the superfamily of cytochrome P450. It is likely to be a key regulator in JA’s biosynthesis [16]. Over-expression of flax AOS in potato led to an increase in endogenous JA level [17]. After wounding, over-expression of AtAOS exhibited an elevated endogenous JA level 2- to 3-fold higher compared with the wild type [18]. Silencing of the NaAOS gene resulted in a JA content decrease in tobacco [19]. Defense gene activation was determined by LeAOS expression in tomato; exogenous MeJA treatment could not activate the expression of wound-inducible PIN II (proteinase inhibitor II) when LeAOS expression was inhibited [20]. Silencing StAOS2 in potato significantly reduced endogenous JA content and compromised disease resistance [21]. Furthermore, AOS was also found acting a positive role in plant drought tolerance. Over-expression of cabbage BaAOS in Arabidopsis increased basal JA levels compared with wild type: with drought stress, transgenic lines exhibited a drastic increase in endogenous JA and higher tolerance [7].
Transcription factor interacts with cis-acting elements in a gene’s promoter region and activates transcription. In watermelon, lots of stress- and hormone-related cis-elements were found in the ClAOS promoter, indicating their possible roles in stress and hormone responses [22]. In Arabidopsis, intact plants showed weak AtAOS1 promoter activity but that significantly increased at 3 h after mechanical wounding, suggesting the AtAOS1 promoter could be an inducible dramatically by injury [23]. Promoter polymorphisms of GmAOS1 associated significantly with soybean defense against common cut worm (Spodoptera litura Fabricius) attack [24].
A large number of AOS genes were cloned and characterized in diverse plants, however, there was still limited information about how it worked [21,25,26]. Our previous study suggested accumulations of JA and proline in citrus increased significantly by drought [27]. In this study, the coding sequence and promoter of AOS1 in trifoliate orange (PtAOS1) were characterized. Gene expression and PtAOS1 promoter activity were detected here. Afterward, a core region contributing to the promoter activity of PtAOS1 was revealed through 5’ deletion assays. Using yeast one-hybrid and dual-fluorescence systems, three interacting proteins binding with the PtAOS1 promoter were identified and named PtDUF886, PtDUF1685 and PtRAP2.4. Responses of PtDUF886, PtDUF1685 and PtRAP2.4 to drought stress were investigated further.
2. Results
2.1. PtAOS1 Gene Expression and its Induction by Drought and JA Treatments
Full-length PtAOS1 was isolated from trifoliate orange. Sequence analysis showed that PtAOS1 encoded a protein of 499 amino acids with a predicted molecular mass of 59.5 kD. The PtAOS1 protein contains a chloroplast transit peptide in N-terminal that might function as a chloroplast localization signal. The phylogenetic tree showed that AOSs were divided into four groups in dicots (Figure 1). Except CsAOS of sweet orange (Citrus sinensis), PtAOS1 exhibited high similarity with pistachio (Pistacia vera) AOS. In addition, AOSs from walnuts (Juglans regia), bayberry (Morella rubra), California valley oak (Quercus lobata), cork oak (Quercus suber) and mulberry (Morus notabilis) were close to PtAOS1 in their evolutionary process.

Figure 1.
Phylogenetic analysis of allene oxide synthase (AOS) proteins among trifoliate orange and other plant species. The phylogenetic tree was constructed by the neighbor-joining method with 1000 replicates of bootstrap values.
Expression patterns of PtAOS1 responding to drought stress and exogenous JA treatment were analyzed. The transcript of PtAOS1 was induced significantly by exogenous JA within 12 h. Peak expression happened at 24 h after JA treatment, about 30-folds higher relative to the control. At 72 h after treatment, PtAOS1 expression decreased sharply, still being about 3.2-folds higher relative to the control (Figure 2A). Expression of PtAOS1 was induced soon after drought stress (Figure 2B). Up-regulation of PtAOS1 was found immediately at 70% soil relative water content (RWC) in which citrus plant grows well generally. From 70% to 50% RWC, its expression level was up-regulated, about 2-folds higher than the control. From 40% to 20% RWC, the PtAOS1 transcript decreased slightly.

Figure 2.
Expression patterns of PtAOS1 in response to jasmonic acid (JA) (A); and drought (B). Data are shown as mean ± SD of three replicates. CK, control samples under well-watered condition. Asterisks indicate significant differences between treatment and control (*, p < 0.05 and **, p < 0.01). Different letters above the columns indicate significant differences at p < 0.05.
2.2. Characterization of PtAOS1 Promoter
The promoter of PtAOS1 containing 1181 bp upstream of the start codon was isolated and analyzed. The promoter fragment typically comprised an element involved in MeJA responsiveness (CGTCA-motif), an abscisic acid responsiveness element (ABRE) and an MYB binding site (MBS) mentioned drought stress (Figure 3). Additionally, cis-acting elements in defense and stress responsiveness (TC-rich repeats) and element essentials for anaerobic induction (ARE) were found also. An element conferring a high transcript level (5UTR Py-rich stretch) was found at −70 to −60 bp upstream of the start codon which might play a vital role in gene expression. A number of light responsive elements existed in the PtAOS1 promoter such as AE-box, box4, BoxI, G-box, GA-motif, MNF1 and Sp1.

Figure 3.
Core elements in the PtAOS1 promoter. The ATG in bold is the start codon of the PtAOS1 gene; the boxed region represents predicted cis-acting elements. 5UTR Py-rich stretch: cis-acting element conferring high transcription levels; A-box: cis-acting regulatory element associated with P- and L-box involved in induced transcriptional activity; ABRE: cis-acting element involved in the abscisic acid responsiveness; AE-box: part of a module for light response; ARE: cis-acting regulatory element essential for the anaerobic induction; Box4: part of a conserved DNA module involved in light responsiveness; Box I: light responsive element; CAAT-box: common cis-acting element in promoter and enhancer regions; CGTCA-motif: cis-acting regulatory element involved in MeJA responsiveness; G-box: cis-acting regulatory element involved in light responsiveness; GA-motif: part of a light responsive element; GT1-motif: light responsive element; MBS: MYB binding Site; MNF1: light responsive element; MRE: MYB binding site involved in light responsiveness; Skn-1_motif: cis-acting regulatory element required for endosperm expression; Sp1: light responsive element; TATA-box: core promoter element around −30 of transcription start; TC-rich repeats: cis-acting element involved in defense and stress responsiveness; TCA-element: cis-acting element involved in salicylic acid responsiveness.
Transient expression assays were used to examine a core region in the PtAOS1 promoter. Promoter P−1181 (−1181 to +1) and its truncated fragments P−1062 (−1062 to +1), P−922 (−922 to +1), P−668 (−668 to +1), P−532 (−532 to +1) and P−265 (−265 to +1) were assigned to drive a yellow fluorescent protein (YFP) in tobacco leaves. A YFP signal driven by P−1182 was detected successfully in tobacco epidermal cells which illustrated the transcription activation of the PtAOS1 promoter. A YFP driven by P−1062, P−922, P−668 and P−532 fragments exposed a fluorescence signal equally with that using P−1182. However, a YFP signal with a P−265 fragment drive decreased sharply, implying a core function lost (Figure 4A–C).

Figure 4.
Construction for the PtAOS1 promoter and transient expression in tobacco leaves. (A) Schematic diagram for the PtAOS1 promoter. Boxes indicate cis-acting element in the promoter; (B) schematic diagrams of the truncated promoter construct; (C) transient expression of yellow fluorescent protein (YFP) driven by truncated promoter fragments in tobacco leaves.
To demonstrate the responses of the PtAOS1 promoter to MeJA and abscisic acid (ABA), 50 µM MeJA and 25 µM ABA were applied on infiltrated tobacco leaves. Results showed YFP was stimulated significantly after MeJA and ABA treatments when most truncated promoters were used except only P−265 (Figure 5). No fluorescent signal was detected at all when a YFP was driven by P−265.

Figure 5.
Responses of truncated PtAOS1 promoters to ABA (abscisic acid) and JA (CK, control samples treated with distilled water). Scale bar in white represents 50 µm.
2.3. Proteins Recognizing PtAOS1 Promoter
The yeast one-hybrid screening system was employed to isolate proteins interacting with the PtAOS1 promoter. Basing on the core region of detection, P−532 was selected for bait vector construction. The minimal inhibitory concentration of Aureobasidin A (AbA) for the bait yeast strain was 300 ng/mL. After a screen in a cDNA library prepared using drought-treated trifoliate orange leaves, three clones exhibited AbA resistance on selective plates (Figure 6A,B). Sequencing for three clones suggested they were PtDUF886, PtDUF1685 and PtRAP2.4, respectively. One-to-one re-transformations for three proteins showed all of the three still grew normally on SD/-Leu medium with 300 ng/mL AbA (Figure 6C). To confirm the interactions, dual luciferase assays were performed additionally. Results suggested that PtDUF886, PtDUF1685 and PtRAP2.4 could enhance P−532 drive activity 2.1-, 3.6- and 4.5-folds higher, respectively, relative to the control (Figure 6D).
Figure 6.
Isolation and identification of proteins interacting with the PtAOS1 promoter. (A) Yeast library transformation and capacity identification; (B) screening and re-selection of positive clones on SD/-Leu with 350 ng/mL AbA; (C) growth of yeast strains co-transformed with prey and bait, negative control (bait/pGADT7) and positive control (p53/pGADT7-53) on selective medium; (D) dual luciferase assay by transient expression in tobacco. Asterisks indicate significant differences between drought treatment and control (*, p < 0.05 and **, p < 0.01).
2.4. Expression Profiles of Three Interacting Proteins under Drought Stress
Expression profiles of three proteins indicated they all responded to drought sensitively in trifoliate orange. Along with RWC decrease, the transcripts of PtRAP2.4 and PtDUF1685 increased and peaked at 50% RWC, and then decreased gradually (Figure 7A,B). Gene PtDUF886 exhibited 2-folds higher expression at 70% and 60% RWC. After a little decrease from 60% to 50% RWC, PtDUF886 expressed stably from 50% to 20% RWC with a still higher expression than that without drought (Figure 7C).

Figure 7.
Expression pattern of PtRAP2.4 (A), PtDUF1685 (B) and PtDUF886 (C) under drought stress. Different letters above the columns indicate significant differences at p < 0.05. CK, control samples under well-watered condition.
3. Discussion
JAs were vital phytohormones participating in plant development and responding to biotic and abiotic stresses. Allene oxide synthase (AOS) catalyzes the first step in JA biosynthesis and the encoding gene works outstandingly after abiotic and biotic stresses [6,23]. Generally, plant drought tolerance correlated with endogenous JA accumulation. Expression of CitAOS in citrus plants increased gradually under drought stress along with JA accumulation [27]. In chickpea, a drought-tolerant variety exhibited earlier activation of MtAOS and higher JA content after drought treatment [28]. Transcriptome analysis revealed that HaAOS in sunflower root was up-regulated under salinity treatment [29]. Expression of AtAOS was rapidly induced at 15–30 min after wounding in Arabidopsis [30]. In tomato, insect chewing would lead to expression increases in both LeAOS and LeHPL [31,32]. Over-expression of AOS genes could improve plant tolerance to biotic and abiotic stress, and that probably works through an endogenous JA increase. Over-expression of the flax AOS gene in potato led to about 8- to 12-fold increase in endogenous JA [33]. With CsAOS2 over-expression in tobacco, higher JA content was detected at 1 h after mechanical damage [34]. Transgenic rice with OsAOS2 exhibited abundant OsAOS2 transcripts and a higher endogenous JA level after pathogen infection [26]. Tobacco with over-expressed TaAOS exhibited higher chlorophyll content and displayed stronger tolerance to ZnCl2 stress [35]. In this study, expression of PtAOS1 was significantly induced by drought in trifoliate orange (Figure 2B) showing a similar characteristic with that in other crops. In addition, PtAOS1 expression was also dramatically up-regulated after JA treatment (Figure 2A) which was believed to enhance plant tolerance to drought. These results indicated that JA and PtAOS1 worked really well in the drought tolerance of trifoliate orange.
It is widely known that a gene expression induced by an external stimulus was modulated by a regulatory motif in the promoter region [36,37,38]. Investigations of promoters help to understand the specificity mechanism of plant genes responding to abiotic stresses. For example, the GmRD26 (a NAC transcription factor) promoter has been characterized as being involved in stress and ABA response; ABRE motifs and ABA responsive elements were thought to be the key factor influencing the stress-responsive gene expression regulated by GmRD26 under drought stress [39]. In transgenic tobacco, disruption of an E-box/ABRE-like motif in the storage protein napA promoter led to the complete abolishment of reporter gene expression, suggesting that E-box is a core motif conferring napA promoter activity [40]. Here, the PtAOS1 promoter contained cis-acting elements engaging in defense and stress responsiveness like an MYB binding site [41] and two phytohormone response elements, a CGTCA-motif and an ABRE element [42]. These implied an integrated way that trifoliate orange responded to drought through the JA pathway. Besides, the PtAOS1 promoter was enriched in some light-responsive elements such as AE-box, G-box and MNF1 motif, indicating possible involvement in light response [43,44].
Identification of a core region in the promoter could be reached by promoter deletion. The grapevine vacuolar processing enzyme VvβVPE promoter was demonstrated as seed-specific, whereas this specificity vanished with a deletion from −1306 to −1045 bp [45]. In rice, sequence −1820 to −1525 bp harboring multiple core cis-acting elements including both CAAT-box and TATA-box was a core region of the OsHAK1 promoter; further, the 5’ deletion analysis demonstrated that the promoter region −3037 to −1821 bp was indispensable for osmotic stress response [46]. In the present work, promoter deletion assays demonstrated that the region −532 to −265 bp was core-functional for the PtAOS1 promoter (Figure 4C). Hormone treatments indicated the PtAOS1 promoter responds to MeJA and ABA well, but the function lost all when the region −532 to −265 bp was absent. These evidences implied that the region −532 to −265 bp was indispensable for whatever PtAOS1 promoter activity or MeJA and ABA responses. Further sequence analysis showed an ABRE element, a CGTCA-motif, three light-responsive elements and three CAAT-box were harbored in this promoter fragment.
Our previous reports suggested that the JA [27] and ABA [47] pathways were two of the causes of drought tolerance in trifoliate orange. CGTCA-motif had been previously identified as a binding site for transcription factors involved in JA signal transduction [48]. GUS activity showed that the prosystemin gene (SlPS) promoter region −221 to +40 bp was sufficient for JA-responsive transcription activation in tomato (Solanum lycopersicum) through a series of 5’ deletions [49]. Similarly, in kiwifruit, a CGTCA-motif in the ascorbic acid (AsA) synthesis gene GGP promoter was deduced to a function of regulating GGP gene expression when subjected to JA [50]. ABRE existing in −532 to −265 bp in the PtAOS1 promoter was known as a major cis-acting regulatory element in ABA-dependent drought tolerance. An ABRE element was required for stress-responsive gene expression induced by osmotic stress in an ABA-dependent pathway. Gene OSBZ8 was considered to regulate ABA-mediated transcription; the intensity of OSBZ8 binding to an ABRE element was high and constitutive in salt-tolerant rice cultivars compared with salt-sensitive cultivars [51]. Expressions of AREB1, AREB2 and ABF3 were induced by drought, ABA treatment and high-salinity in Arabidopsis: these three genes functioned as transcription activators in ABA-dependent response through directly binding to an ABRE sequence in the DREB2A promoter [52]. In this study, JA enhanced PtAOS1 promoter activity but the inducibility was significantly reduced by a 268 bp deletion which contained a CGTCA-motif and an ABRE-element. These results demonstrated a CGTCA-motif and an ABRE-element located in −532 to −265 bp of PtAOS1 promoter could be responsible for the JA drought response in trifoliate orange.
Limited information is known about AOS gene regulation. A recent report revealed a JAV1-JAZ8-WRKY51 (JJW) complex repressing JA biosynthesis through binding to the AtAOS promoter in healthy Arabidopsis. However, the JJW complex would disintegrate and activate JA biosynthesis once the plant was injured by mechanical damage or insect attack [53]. Similarly, OsDOF24 acted as a repressor for rice leaf senescence through binding directly to the OsAOS1 promoter. A reduction in endogenous JA by over-expressed OsDOF24 affected multiple physiological processes including leaf senescence, plant architecture and grain yield [54]. Here, we constructed and screened a cDNA library of trifoliate orange using the PtAOS1 promoter bait, and three interacting proteins PtDUF886, PtDUF1685 and PtRAP2.4 were obtained (Figure 6A–C). The dual luciferase assay demonstrated all three transcription factors could enhance promoter activity, suggesting their positive roles in JA biosynthesis (Figure 6D). Domain of unknown function (DUF) proteins belong to a large uncharacterized protein family in the Pfam database [55]. The transcript level of OsDUF810.7 was significantly induced by drought in rice: over-expression of OsDUF810.7 in E. coli improved bacterial tolerance to salt and drought by enhancing antioxidant activities [56]. Expression levels of OsDUF829.2 and OsDUF829.4 in rice were significantly induced by salt and heat stress: over-expressions of them in E.coli improved its resistance to salt stress [57]. Expression of DUF1618 genes differed in diverse rice cultivars and in responding to stress and hormone treatments [58]. In the present work, PtDUF1685 and PtDUF886 encoding two uncharacterized proteins, and transcripts of them were induced significantly by drought in trifoliate orange (Figure 7B,C). Our results indicated that PtDUF1685 and PtDUF886 probably functioned in drought tolerance through transcriptional regulation to PtAOS1 in trifoliate orange. ERF transcription factors have been known to work in ethylene signal transduction and dehydration response [59,60,61,62]. Gene GmERF3 expression was induced by abiotic stress (high-salinity and drought) and plant hormones (JA, SA, ET and ABA) in soybean; over-expression of GmERF3 in tobacco improved its drought tolerance [63]. Similarly, over-expression of TaERF3 in wheat also exhibited tolerance enhancement to salt and drought stresses [64]. Several ERF transcription factors were also found to be involved in JA signaling. Gene ORCA3 encoding an AP2/ERF transcription factor was involved in JA signaling via directly binding to the jasmonate- and elicitor-responsive element of the Strictosidine synthase gene promoter [65]. ERF member ORA59 acted as the key regulator of JA and ET responsiveness [66]. Genes AaERF1 and AaERF2 from Artemisia annua were both strongly induced by JA and acted as positive regulators of artemisinin biosynthesis [67]. Here, PtRAP2.4 with an AP2 domain was an AP2/ERF transcription factor and its expression was induced by drought significantly (Figure 7A). It could be concluded that PtRAP2.4 played roles in not only the regulation of JA biosynthesis but also the crosstalk between the JA and ethylene signals. In this study, three proteins interacting with the PtAOS1 promoter were identified and this probably offers new insights for JA responding to drought. These findings also help to understand more about drought tolerance of trifoliate orange and provide more information for citrus rootstock breeding. Drought stress would lead to multiple physiological and biochemical changes in diverse pathways. It would be essential to characterize these three novel proteins in regulating gene expressions, modulating JA synthesis and effecting an antioxidant system and so on. All the above contribute to a better understanding in the regulatory mechanism of trifoliate orange to drought stress.
In conclusion, we identified and analyzed PtAOS1 from trifoliate orange which was induced by drought, ABA treatment and JA treatment. A region from −532 to −265 bp in the PtAOS1 promoter was indispensable for promoter activity and ABA and JA responses. An ABRE element and a CGTCA-motif in the PtAOS1 promoter were probably responsible for PtAOS1 responding to drought. Further, three novel proteins which were drought-inducible and worked through binding to the PtAOS1 promoter were identified. These findings may offer new insights into the drought tolerance of trifoliate orange through the JA pathway.
4. Materials and Methods
4.1. Plant Materials and Treatments
Six-month-old trifoliate orange (Poncirus trifoliate) seedlings in this assay were planted in a green house. All tobacco (Nicotiana benthamiana) seedlings were grown in a plant growth chamber with 16 h light/8 h dark cycle at 28 °C.
For drought treatment, trifoliate orange seedlings planted in a premix substrate were treated with no watering. Samples were collected when the relative water content of the substrate descended to 70%, 60%, 50%, 40%, 30% and 20%, respectively, detected by a soil moisture meter TDR 300 (Spectrum Technologies, Alpharetta, GA, USA). Control samples (CK) were collected from well-watered seedlings.
One mM MeJA was sprayed on the leaves of trifoliate orange. Samples were collected at 0, 12, 24 and 72 h after treatment. All samples were stored at −80 °C until use.
4.2. Cloning and Expression Pattern of PtAOS
The PtAOS1 open reading frame (ORF) was PCR-amplified from trifoliate orange cDNA with primers (forward 5′-ATGGCATCCACTTCTCTATCTTT-3′, reverse 5′-AAAGCTTG CTCTCTTCAACGAC-3′) and constructed into a pM18-T vector (Takara, Dalian, China). The NCBI (http://www.ncbi.nl m.nih.gov/) database was used for a homologous sequence search through the BLAST program and protein sequences were aligned with the ClustalW 2.0 software. The phylogenetic tree for AOS proteins was constructed with the MEGA5.0 software using the neighbor-joining method. Chloroplast transit peptide was analyzed using TargetP (http://www.cb s.dtu.dk/services/TargetP) and ChloroP (http://www.cbs.dtu.dk/services/ChloroP/).
Gene expression patterns were assayed using mature leaves. Total RNA was isolated using RNAprep Pure Plant Kit (Tiangen, Beijing, China) according to the manufacturer’s protocol. The first strand of cDNA was synthesized from 1 µg of DNase treated total RNA using FastQuant RT Kit (Tiangen, Beijing, China) according to the manufacturer’s instruction. The primers used in the real-time quantitative PCR (qPCR) were as follows: PtAOS1 (forward 5′-CCGTGTTCTGTCGTATCTTG-3′, reverse 5′-CCGTGTAGGTGGAGTGAA-3′), PtDUF668 (forward 5′-CGAGCCA ATAGCCTATCAGT-3′, reverse 5′-GCTTCCACTCCAGATTATTCAC-3′), PtDUF1685 (forward 5′-TGAGCATCAGAGCCAGAA-3′, reverse 5′-GATCGCCAGGACTAGAGAT-3′) and PtRAP2.4 (forward 5′-AATGGCGGCTACAATGGATT-3′, reverse 5′-GGAGAAGCAGTTGGTGAAGT-3′). The qPCR was performed with SsoAdvancedTM SYBR® Green Supermix (Bio-Rad, Hercules, CA, USA) using the CFX96 system (Bio-Rad, Hercules, CA, USA). The reaction mixture (total volume 10 µL) comprised 1 µL cDNA template, 0.5 µL primers (0.25 µM forward and 0.25 µM reverse), 5 µL 2× SYBR Green Supermix and 3.5 µL RNase-free water. The cycling parameters were 30 s at 95 °C, followed by 40 cycles of 95 °C for 5 s, 58 °C for 15 s. The relative expression level was normalized against the β-actin gene. Relative gene expression was calculated using the CFX96 software. Three biological replicates were performed for each sample.
4.3. Promoter Isolation and Vector Construction
Total genome DNA was extracted from trifoliate orange leaves using Plant Genomic DNA Extraction Kit (Takara, Dalian, China). The PtAOS1 promoter was amplified using primers (forward 5′-CCTCTCCTCTTACTCTTCTC-3′, reverse 5′-TTCACAGCGATAATAATTGTTGT-3′) and cloned into a pMD18-T vector for sequencing. Core motif predicted by PlantCARE (http://bioinformatics.ps b.ugent.be/webtools/plantcare/html). The promoter of PtAOS1 and truncated fragments (−1062 to +1, −922 to +1, −668 to +1, −532 to +1, −265 to +1) were PCR-amplified using a specific forward primer (F−1062 5′-GAATTCAGACGACCAGCTTATGGCAAA-3′, F−922 5′-GAATTCCTACTTGAGTTTGC GCCTT-3′, F−668 5′-GAATTCCGTGGGCAATGCACTAGCCTA-3′, F−532 5′-GAATTCAAATTGCAC CTATCAGCGTCA-3′, F−265 5′-GAATTCTTGAAATGTTACGACTTGCGACT-3′) and the same reverse primer (5′-GGATCCTTCACAGCGATAATAATTGTTGT-3′). The PCR products were gel-purified and cloned into a modified pBI121-YFP vector with EcoRI and BamHI digestion. The corresponding vectors were named P−1181, P−1062, P−922, P−688, P−532 and P−265, respectively. All constructs were purified and transformed into agrobacterium (EHA105) for further transient expression.
4.4. Agrobacterium-Mediate Transient Expression in Tobacco
With Nicotiana benthamiana, the transient expression assay was performed as according to Sparkes [68] with minor modification. Strains preparation: streaking the corresponding agrobacterium strains on LB plates, incubate at 28 °C for 2 days. A single strain was selected and transferred into 3 mL liquid LB medium with 8 h shaking. This was followed by subsequent shaking in 50 mL LB until OD600 reached 0.6. Then, it was centrifuged at 3000 rpm and resuspended with infiltration buffer containing 10 mM 2-Morpholino ethanesulfonic acid hydrate (MES), 10 mM MgCl2 and 100 µM acetosyringone to an OD600 of 0.8, followed by incubating at 28 °C for 2 h. Infiltration: tobaccos leaves were injected from the back with a syringe (needle removed) until the water spots spread all over them. After 3 days, the YFP fluorescence intensity was detected with the LSM700 Fluorescence microscope (Zeiss, Oberkochen, Germany). Phytohormone treatment: tobacco leaves were treated with distilled water (CK), 50 µM MeJA or 25 µM abscisic acid (ABA) at 12 h after the infiltration, and the YFP signal was detected at 36 h after treatment.
4.5. Construction and Screening of a cDNA Library
The P−532 fragment of the PtAOS promoter was cloned into a pAbAi vector with digestion by SacI and XhoI. The construct was then digested by SmaI and then transformed into yeast strain Y1HGold according to the Matchmaker™ Gold Yeast One-Hybrid System (Clontech, Mountain View, CA, USA) protocol and selected on dropout medium lacking uracil (SD/-Ura). A positive yeast strain was then picked and resuspended in 0.9% NaCl to an OD600 of 0.002. Then, SD/-Ura with Aureobasidin A (AbA) medium was used to determine the minimal AbA inhibitory concentration. The cDNA library construction was performed following the manufacturer’s instruction for the MatchmakerTM Gold Yeast One-Hybrid Library Screening System (Clontech, Mountain View, CA, USA). First, total RNA was extracted from trifoliate orange leaves using the method described before, and then mRNA was enriched and purified. Then, a cDNA for library construction was generated through first-strand SMART cDNA synthesis and long-distance PCR for double-strand cDNA (ds cDNA). The ds cDNA was purified with CHROMA SPIN+TE-400 columns. A one-hybrid cDNA library (20 µL SMART-amplified ds cDNA, 6 µL pGADT7-Rec) screen was performed according to yeast maker transformation system two. Library transformation reactions were spread on SD/-Leu with 300 mg/mL AbA with incubation at 30 °C for 3–5 days. Positive interaction clones were rescued and prey plasmids were isolated from selective plates. To quickly identify the clones, the T7 primer was used for sequencing, and plasmids were retransformed into bait yeast to confirm the interaction.
4.6. Dual Luciferase Assay
Full-length genes of PtDUF886, PtDUF1685 and PtRAP2.4 were amplified from trifoliate orange cDNA with gene-specific primers and cloned into the effector vector pGreenII 62-SK. The clone primers used were as follows: PtDUF886 (forward 5’-GGATCCATGACATTTTCTTCTCCAATTCTC-3’, reverse 5’-GGATCCCCAATTGAGTTTCACCAGCTTCCAC-3’), PtDUF1685 (forward 5’-GGATCCATGGGACGCTTTTCTTGTGA-3’, reverse 5’-GGATCCGCTGCACAACCTAACAG-3’) and PtRAP2.4 (forward 5’-GGATCCATGGCGGCTACAATGGATTTC-3’, reverse 5’-GGATCCAGATAATATTGAAGCCCAATCA-3’). The P−532 fragment of the PtAOS1 promoter was amplified and ligated into the reporter vector pGreenII 0800-LUC. The corresponding constructs were transformed into GV3101 component cells. Effector and reporter strains were separately re-cultivated on an LB plate with 50 mg/L kanamycin at 28 °C for 48 h. We resuspended the colony in MES buffer to an OD600 of 0.8 and incubated it for 2 h at 28 °C. Resuspended effector: reporter = 5:1 before infiltration was mixed up. After infiltration, tobacco seedings were moved back to the growth chamber with no watering for 3 days. Activity assays for firefly luciferase (LUC) and renilla luciferase (REN) were performed via the Dual-luciferase Reporter Assay System (Promega, Madison, WI, USA) according to the manufacturer’s instruction.
4.7. Statistical Analysis
All data were presented as mean ± SE with three independent replicates at least. The data were analyzed using the SPSS13.0 software running ANOVA according to Tukey’s multiple range test taking p < 0.05 as statistically significant.
Author Contributions
Conceptualization, J.X., S.X. and X.L. (Xiaopeng Lu); methodology, J.X.; software, J.X. and L.L.; validation, X.M., C.T., Z.L., F.L., B.L., T.Z., M.T., X.L. (Xuefei Lian) and Y.C.; formal analysis, J.X. and X.L. (Xiaopeng Lu); investigation, J.X. and L.L.; resources, J.X. and X.L. (Xiaopeng Lu); data curation, J.X., L.L., and X.L. (Xiaopeng Lu); writing—original draft preparation, J.X.; writing—review and editing, J.X. and X.L. (Xiaopeng Lu); supervision, X.L. (Xiaopeng Lu); project administration, J.X.; funding acquisition, S.X. and X.L (Xiaopeng Lu). All authors have read and agreed to the published version of the manuscript.
Funding
This work was supported by the National Natural Science Foundation of China (31872044), China Agriculture (Citrus) Research System (CARS-26) and the Natural Science Funding of Hunan Province (2018JJ3232).
Acknowledgments
The authors thank Cui Xiao (Hubei Academy of Agriculture Sciences, Wuhan, China) for kindly providing us the vectors for transient expression assay.
Conflicts of Interest
The authors declare no conflict of interest.
References
- He, Y.; Fukushige, H.; Hildebrand, D.F.; Gan, S. Evidence supporting a role of jasmonic acid in Arabidopsis leaf senescence. Plant Physiol. 2002, 128, 876–884. [Google Scholar] [CrossRef] [PubMed]
- Helder, H.; Miersch, O.; Vreugdenhil, D.; Sembdner, G. Occurrence of hydroxylated jasmonic acids in leaflets of Solanum demissum plants grown under long- and short-day conditions. Physiol. Plant 1993, 88, 647–653. [Google Scholar] [CrossRef]
- Falkenstein, E.; Groth, B.; Mithofer, A.; Weiler, E.W. Methyljasmonate and alpha-linolenic acid are potent inducers of tendril coiling. Planta 1991, 185, 316–322. [Google Scholar] [CrossRef] [PubMed]
- Stintzi, A.; Browse, J. The Arabidopsis male-sterile mutant, opr3, lacks the 12-oxophytodienoic acid reductase required for jasmonate synthesis. Proc. Natl. Acad. Sci. USA 2000, 97, 10625–10630. [Google Scholar] [CrossRef]
- Toyoda, K.; Kawanishi, Y.; Kawamoto, Y.; Kurihara, C.; Yamagishi, N.; Tamura, A.; Yoshikawa, N.; Inagaki, Y.; Ichinose, Y.; Shiraishi, T. Suppression of mRNAs for lipoxygenase (LOX), allene oxide synthase (AOS), allene oxide cyclase (AOC) and 12-oxo-phytodienoic acid reductase (OPR) in pea reduces sensitivity to the phytotoxin coronatine and disease development by Mycosphaerella pinodes. J. Gen. Plant Pathol. 2013, 79, 321–334. [Google Scholar] [CrossRef]
- Naor, N.; Gurung, F.B.; Ozalvo, R.; Bucki, P.; Sanadhya, P.; Miyara, S.B. Tight regulation of allene oxide synthase (AOS) and allene oxide cyclase-3 (AOC3) promote Arabidopsis susceptibility to the root-knot nematode Meloidogyne javanica. Eur. J. Plant Pathol. 2018, 150, 149–165. [Google Scholar] [CrossRef]
- Wu, X.; Li, D.; Wang, J.; Shi, J.; Li, R.; Zhao, B.; Ren, S.; Guo, Y.D. Cloning and characterization of a cabbage BoAOS gene with enhanced drought tolerance. N. Z. J. Crop Hort. Sci. 2015, 43, 32–41. [Google Scholar] [CrossRef]
- Alam, M.M.; Nahar, K.; Hasanuzzaman, M.; Fujita, M. Exogenous jasmonic acid modulates the physiology, antioxidant defense and glyoxalase systems in imparting drought stress tolerance in different Brassica species. Plant Biotechnol. Rep. 2014, 8, 279–293. [Google Scholar] [CrossRef]
- Shan, C.; Zhou, Y.; Liu, M. Nitric oxide participates in the regulation of the ascorbate-glutathione cycle by exogenous jasmonic acid in the leaves of wheat seedlings under drought stress. Protoplasma 2015, 252, 1397–1405. [Google Scholar] [CrossRef]
- Mohamed, H.I.; Latif, H.H. Improvement of drought tolerance of soybean plants by using methyl jasmonate. Physiol. Mol. Biol. Plants 2017, 23, 545–556. [Google Scholar] [CrossRef]
- Kazan, K. Diverse roles of jasmonates and ethylene in abiotic stress tolerance. Trends Plant Sci. 2015, 20, 219–229. [Google Scholar] [CrossRef] [PubMed]
- Pedranzani, H.; Racagni, G.; Alemano, S.; Miersch, O.; Ramírez, I.; Peña-Cortés, H.; Taleisnik, E.; Machado-Domenech, E.; Abdala, G. Salt tolerant tomato plants show increased levels of jasmonic acid. Plant Growth Regul. 2003, 41, 149–158. [Google Scholar] [CrossRef]
- Shahzad, A.N.; Pitann, B.; Ali, H.; Qayyum, M.F.; Fatima, A.; Bakhat, H.F. Maize Genotypes Differing in Salt Resistance Vary in Jasmonic Acid Accumulation During the First Phase of SaltStress. J. Agron. Crop. Sci. 2015, 201, 443–451. [Google Scholar] [CrossRef]
- Qiu, Z.; Guo, J.; Zhu, A.; Zhang, L.; Zhang, M. Exogenous jasmonic acid can enhance tolerance of wheat seedlings to salt stress. Ecotoxicol. Environ. Saf. 2014, 104, 202–208. [Google Scholar] [CrossRef] [PubMed]
- Abouelsaad, I.; Renault, S. Enhanced oxidative stress in the jasmonic acid-deficient tomato mutant def-1 exposed to NaCl stress. J. Plant Physiol. 2018, 226, 136–144. [Google Scholar] [CrossRef]
- Laudert, D.; Weiler, E.W. Allene oxide synthase: A major control point in Arabidopsis thaliana octadecanoid signalling. Plant J. 1998, 15, 675–684. [Google Scholar] [CrossRef]
- Song, W.C.; Brash, A.R. Purification of an allene oxide synthase and identification of the enzyme as a cytochrome P-450. Science 1991, 253, 781–784. [Google Scholar] [CrossRef]
- Laudert, D.; Schaller, F.; Weiler, E.W. Transgenic Nicotiana tabacum and Arabidopsis thaliana plants overexpressing allene oxide synthase. Planta 2000, 211, 163–165. [Google Scholar] [CrossRef]
- Halitschke, R.; Ziegler, J.; Keinanen, M.; Baldwin, I.T. Silencing of hydroperoxide lyase and allene oxide synthase reveals substrate and defense signaling crosstalk in Nicotiana attenuata. Plant J. 2004, 40, 35–46. [Google Scholar] [CrossRef]
- Sivasankar, S.; Sheldrick, B.; Rothstein, S.J. Expression of allene oxide synthase determines defense gene activation in tomato. Plant Physiol. 2000, 122, 1335–1342. [Google Scholar] [CrossRef]
- Pajerowska-Mukhtar, K.M.; Mukhtar, M.S.; Guex, N.; Halim, V.A.; Rosahl, S.; Somssich, I.E.; Gebhardt, C. Natural variation of potato allene oxide synthase 2 causes differential levels of jasmonates and pathogen resistance in Arabidopsis. Planta 2008, 228, 293–306. [Google Scholar] [CrossRef] [PubMed]
- Zhou, Y.; Guang, Y.L.; Li, J.W.; Wang, F.; Ahammed, G.J.; Yang, Y.X. The CYP74 Gene Family in Watermelon: Genome-Wide Identification and Expression Profiling Under Hormonal Stress and Root-Knot Nematode Infection. Agronomy 2019, 9, 872. [Google Scholar] [CrossRef]
- Mwenda, C.M.; Matsuki, A.; Nishimura, K.; Koeduka, T.; Matsui, K. Spatial expression of the Arabidopsis hydroperoxide lyase gene is controlled differently from that of the allene oxide synthase gene. J. Plant Interact. 2015, 10, 1–10. [Google Scholar] [CrossRef]
- Wang, H.; Gao, Z.J.; Liu, H.L.; Wu, J.J.; Yu, D.Y. Variation in GmAOS1 promoter is associated with soybean defense against insect attack. Euphytica 2014, 196, 365–374. [Google Scholar] [CrossRef]
- Bandara, P.K.; Takahashi, K.; Sato, M.; Matsuura, H.; Nabeta, K. Cloning and functional analysis of an allene oxide synthase in Physcomitrella patens. Biosci. Biotechnol. Biochem. 2009, 73, 2356–2359. [Google Scholar]
- Mei, C.; Qi, M.; Sheng, G.; Yang, Y. Inducible overexpression of a rice allene oxide synthase gene increases the endogenous jasmonic acid level, PR gene expression, and host resistance to fungal infection. Mol. Plant Microbe Interact. 2006, 19, 1127–1137. [Google Scholar] [CrossRef]
- Zhao, X.; Lu, X.; Nie, Q.; Huang, C.; Xiao, Y.; Xie, S. Effect of Water Stress on Physiological Characteristics, JA Biosynthesis and Correlative Genes Expression in Citrus. Acta Agric. Univ. Jiangxiensis 2013, 35, 530–535. [Google Scholar]
- De Domenico, S.; Bonsegna, S.; Horres, R.; Pastor, V.; Taurino, M.; Poltronieri, P.; Imtiaz, M.; Kahl, G.; Flors, V.; Winter, P.; et al. Transcriptomic analysis of oxylipin biosynthesis genes and chemical profiling reveal an early induction of jasmonates in chickpea roots under drought stress. Plant Physiol. Biochem. 2012, 61, 115–122. [Google Scholar] [CrossRef]
- Wang, P.; Ma, L.L.; Li, Y.; Wang, S.A.; Li, L.F.; Yang, R.T. Transcriptome analysis reveals sunflower cytochrome P450 CYP93A1 responses to high salinity treatment at the seedling stage. Genes Genom. 2017, 39, 581–591. [Google Scholar] [CrossRef]
- Laudert, D.; Pfannschmidt, U.; Lottspeich, F.; Hollander-Czytko, H.; Weiler, E.W. Cloning, molecular and functional characterization of Arabidopsis thaliana allene oxide synthase (CYP 74), the first enzyme of the octadecanoid pathway to jasmonates. Plant Mol. Biol. 1996, 31, 323–335. [Google Scholar] [CrossRef]
- Howe, G.A.; Lee, G.I.; Itoh, A.; Li, L.; DeRocher, A.E. Cytochrome P450-dependent metabolism of oxylipins in tomato. Cloning and expression of allene oxide synthase and fatty acid hydroperoxide lyase. Plant Physiol. 2000, 123, 711–724. [Google Scholar] [CrossRef] [PubMed]
- Dumin, W.; Rostas, M.; Winefield, C. Identification and functional characterisation of an allene oxide synthase from grapevine (Vitis vinifera L. Sauvignon blanc). Mol. Biol. Rep. 2018, 45, 263–277. [Google Scholar] [CrossRef] [PubMed]
- Harms, K.; Atzorn, R.; Brash, A.; Kühn, H.; Wasternack, C.; Willmitzer, L.; Pena-Cortés, H. Expression of a Flax Allene Oxide Synthase cDNA Leads to Increased Endogenous Jasmonic Acid (JA) Levels in Transgenic Potato Plants but Not to a Corresponding Activation of JA-Responding Genes. Plant Cell 1995, 7, 1645–1654. [Google Scholar] [CrossRef]
- Peng, Q.; Zhou, Y.; Liao, Y.; Zeng, L.; Xu, X.; Jia, Y.; Dong, F.; Li, J.; Tang, J.; Yang, Z. Functional Characterization of An Allene Oxide Synthase Involved in Biosynthesis of Jasmonic Acid and Its Influence on Metabolite Profiles and Ethylene Formation in Tea (Camellia sinensis) Flowers. Int. J. Mol. Sci. 2018, 19. [Google Scholar] [CrossRef]
- Liu, H.H.; Wang, Y.G.; Wang, S.P.; Li, H.J.; Xin, Q.G. Improved zinc tolerance of tobacco by transgenic expression of an allene oxide synthase gene from hexaploid wheat. Acta Physiol. Plant. 2014, 36, 2433–2440. [Google Scholar] [CrossRef]
- Yamaguchi-Shinozaki, K.; Shinozaki, K. Organization of cis-acting regulatory elements in osmotic- and cold-stress-responsive promoters. Trends Plant Sci. 2005, 10, 88–94. [Google Scholar] [CrossRef] [PubMed]
- Novina, C.D.; Roy, A.L. Core promoters and transcriptional control. Trends Genet. 1996, 12, 351–355. [Google Scholar] [CrossRef]
- Hernandez-Garcia, C.M.; Finer, J.J. Identification and validation of promoters and cis-acting regulatory elements. Plant Sci. 2014, 217–218, 109–119. [Google Scholar] [CrossRef]
- Freitas, E.O.; Melo, B.P.; Lourenco-Tessutti, I.T.; Arraes, F.B.M.; Amorim, R.M.; Lisei-de-Sa, M.E.; Costa, J.A.; Leite, A.G.B.; Faheem, M.; Ferreira, M.A.; et al. Identification and characterization of the GmRD26 soybean promoter in response to abiotic stresses: Potential tool for biotechnological application. BMC Biotechnol. 2019, 19, 79. [Google Scholar] [CrossRef]
- Stalberg, K.; Ellerstom, M.; Ezcurra, I.; Ablov, S.; Rask, L. Disruption of an overlapping E-box/ABRE motif abolished high transcription of the napA storage-protein promoter in transgenic Brassica napus seeds. Planta 1996, 199, 515–519. [Google Scholar] [CrossRef]
- Baranowskij, N.; Frohberg, C.; Prat, S.; Willmitzer, L. A novel DNA binding protein with homology to Myb oncoproteins containing only one repeat can function as a transcriptional activator. EMBO J. 1994, 13, 5383–5392. [Google Scholar] [CrossRef] [PubMed]
- Kaplan, B.; Davydov, O.; Knight, H.; Galon, Y.; Knight, M.R.; Fluhr, R.; Fromm, H. Rapid transcriptome changes induced by cytosolic Ca2+ transients reveal ABRE-related sequences as Ca2+-responsive cis elements in Arabidopsis. Plant Cell 2006, 18, 2733–2748. [Google Scholar] [CrossRef]
- Roy, S.; Choudhury, S.R.; Singh, S.K.; Das, K.P. Functional analysis of light-regulated promoter region of AtPollambda gene. Planta 2012, 235, 411–432. [Google Scholar] [CrossRef]
- Morishima, A. Identification of preferred binding sites of a light-inducible DNA-binding factor (MNF1) within 5′-upstream sequence of C4-type phosphoenolpyruvate carboxylase gene in maize. Plant Mol. Biol. 1998, 38, 633–646. [Google Scholar] [CrossRef] [PubMed]
- Gong, P.; Wei, R.; Li, Y.; Wang, R.; Tang, Y.; Wang, L.; Zhu, H.; Wang, Y.; Zhang, C. Molecular cloning and functional characterization of a seed-specific VvbetaVPE gene promoter from Vitis vinifera. Planta 2019, 250, 657–665. [Google Scholar] [CrossRef] [PubMed]
- Chen, G.; Hu, J.; Lian, J.; Zhang, Y.; Zhu, L.; Zeng, D.L.; Guo, L.B.; Yu, L.; Xu, G.H.; Qian, Q. Functional characterization of OsHAK1 promoter in response to osmotic/drought stress by deletion analysis in transgenic rice. Plant Growth Regul. 2019, 88, 241–251. [Google Scholar] [CrossRef]
- Zhang, Q.; Wang, M.; Hu, J.; Wang, W.; Fu, X.; Liu, J.H. PtrABF of Poncirus trifoliata functions in dehydration tolerance by reducing stomatal density and maintaining reactive oxygen species homeostasis. J. Exp. Bot. 2015, 66, 5911–5927. [Google Scholar] [CrossRef]
- Rouster, J.; Leah, R.; Mundy, J.; Cameron-Mills, V. Identification of a methyl jasmonate-responsive region in the promoter of a lipoxygenase 1 gene expressed in barley grain. Plant J. 1997, 11, 513–523. [Google Scholar] [CrossRef]
- Aviles-Arnaut, H.; Delano-Frier, J.P. Characterization of the tomato prosystemin promoter: Organ-specific expression, hormone specificity and methyl jasmonate responsiveness by deletion analysis in transgenic tobacco plants. J. Integr. Plant Biol. 2012, 54, 15–32. [Google Scholar] [CrossRef]
- Li, J.; Liang, D.; Li, M.; Ma, F. Light and abiotic stresses regulate the expression of GDP-L-galactose phosphorylase and levels of ascorbic acid in two kiwifruit genotypes via light-responsive and stress-inducible cis-elements in their promoters. Planta 2013, 238, 535–547. [Google Scholar] [CrossRef]
- Mukherjee, K.; Choudhury, A.R.; Gupta, B.; Gupta, S.; Sengupta, D.N. An ABRE-binding factor, OSBZ8, is highly expressed in salt tolerant cultivars than in salt sensitive cultivars of indica rice. BMC Plant Biol. 2006, 6, 18. [Google Scholar] [CrossRef]
- Choi, H.; Hong, J.; Ha, J.; Kang, J.; Kim, S.Y. ABFs, a family of ABA-responsive element binding factors. J. Biol. Chem. 2000, 275, 1723–1730. [Google Scholar] [CrossRef] [PubMed]
- Yan, C.; Fan, M.; Yang, M.; Zhao, J.; Zhang, W.; Su, Y.; Xiao, L.; Deng, H.; Xie, D. Injury Activates Ca2+ /Calmodulin-Dependent Phosphorylation of JAV1-JAZ8-WRKY51 Complex for Jasmonate Biosynthesis. Mol. Cell 2018, 70, 136–149. [Google Scholar] [CrossRef] [PubMed]
- Shim, Y.; Kang, K.; An, G.; Paek, N.C. Rice DNA-Binding One Zinc Finger 24 (OsDOF24) Delays Leaf Senescence in a Jasmonate-Mediated Pathway. Plant Cell Physiol. 2019, 60, 2065–2076. [Google Scholar] [CrossRef] [PubMed]
- Bateman, A.; Coggill, P.; Finn, R.D. DUFs: Families in search of function. Acta Crystallogr. Sect. F Struct. Biol. Cryst. Commun. 2010, 66, 1148–1152. [Google Scholar] [CrossRef]
- Li, L.H.; Lv, M.M.; Li, X.; Ye, T.Z.; He, X.; Rong, S.H.; Dong, Y.L.; Guan, Y.; Gao, X.L.; Zhu, J.Q.; et al. The Rice OsDUF810 Family: OsDUF810.7 May be Involved in the Tolerance to Salt and Drought. Mol. Biol. 2018, 52, 489–496. [Google Scholar] [CrossRef]
- Li, L.H.; Lv, M.M.; Zhao, L.; Ye, T.Z.; Xu, J.H.; Cai, L.J.; Xie, C.; Gao, X.L.; Huang, Z.J.; Zhu, J.Q.; et al. Molecular characterization and function analysis of the rice OsDUF829 family. Biotechnol. Biotechnol. Equip. 2018, 32, 550–557. [Google Scholar] [CrossRef]
- Wang, L.; Shen, R.; Chen, L.T.; Liu, Y.G. Characterization of a novel DUF1618 gene family in rice. J. Integr. Plant Biol. 2014, 56, 151–158. [Google Scholar] [CrossRef]
- Sakuma, Y.; Liu, Q.; Dubouzet, J.G.; Abe, H.; Shinozaki, K.; Yamaguchi-Shinozaki, K. DNA-binding specificity of the ERF/AP2 domain of Arabidopsis DREBs, transcription factors involved in dehydration- and cold-inducible gene expression. Biochem. Biophys. Res. Commun. 2002, 290, 998–1009. [Google Scholar] [CrossRef]
- Pre, M.; Atallah, M.; Champion, A.; De Vos, M.; Pieterse, C.M.; Memelink, J. The AP2/ERF domain transcription factor ORA59 integrates jasmonic acid and ethylene signals in plant defense. Plant Physiol. 2008, 147, 1347–1357. [Google Scholar] [CrossRef]
- Mizoi, J.; Shinozaki, K.; Yamaguchi-Shinozaki, K. AP2/ERF family transcription factors in plant abiotic stress responses. Biochim. Biophys. Acta 2012, 1819, 86–96. [Google Scholar] [CrossRef] [PubMed]
- Vogel, M.O.; Moore, M.; Konig, K.; Pecher, P.; Alsharafa, K.; Lee, J.; Dietz, K.J. Fast retrograde signaling in response to high light involves metabolite export, MITOGEN-ACTIVATED PROTEIN KINASE6, and AP2/ERF transcription factors in Arabidopsis. Plant Cell 2014, 26, 1151–1165. [Google Scholar] [CrossRef] [PubMed]
- Zhang, G.; Chen, M.; Li, L.; Xu, Z.; Chen, X.; Guo, J.; Ma, Y. Overexpression of the soybean GmERF3 gene, an AP2/ERF type transcription factor for increased tolerances to salt, drought, and diseases in transgenic tobacco. J. Exp. Bot. 2009, 60, 3781–3796. [Google Scholar] [CrossRef] [PubMed]
- Rong, W.; Qi, L.; Wang, A.; Ye, X.; Du, L.; Liang, H.; Xin, Z.; Zhang, Z. The ERF transcription factor TaERF3 promotes tolerance to salt and drought stresses in wheat. Plant Biotechnol. J. 2014, 12, 468–479. [Google Scholar] [CrossRef] [PubMed]
- Van der Fits, L.; Memelink, J. The jasmonate-inducible AP2/ERF-domain transcription factor ORCA3 activates gene expression via interaction with a jasmonate-responsive promoter element. Plant J. 2001, 25, 43–53. [Google Scholar] [CrossRef] [PubMed]
- Zarei, A.; Korbes, A.P.; Younessi, P.; Montiel, G.; Champion, A.; Memelink, J. Two GCC boxes and AP2/ERF-domain transcription factor ORA59 in jasmonate/ethylene-mediated activation of the PDF1.2 promoter in Arabidopsis. Plant Mol. Biol. 2011, 75, 321–331. [Google Scholar] [CrossRef]
- Yu, Z.X.; Li, J.X.; Yang, C.Q.; Hu, W.L.; Wang, L.J.; Chen, X.Y. The jasmonate-responsive AP2/ERF transcription factors AaERF1 and AaERF2 positively regulate artemisinin biosynthesis in Artemisia annua L. Mol. Plant 2012, 5, 353–365. [Google Scholar] [CrossRef]
- Sparkes, I.A.; Runions, J.; Kearns, A.; Hawes, C. Rapid, transient expression of fluorescent fusion proteins in tobacco plants and generation of stably transformed plants. Nat. Protoc. 2006, 1, 2019–2025. [Google Scholar] [CrossRef]
© 2020 by the authors. Licensee MDPI, Basel, Switzerland. This article is an open access article distributed under the terms and conditions of the Creative Commons Attribution (CC BY) license (http://creativecommons.org/licenses/by/4.0/).







